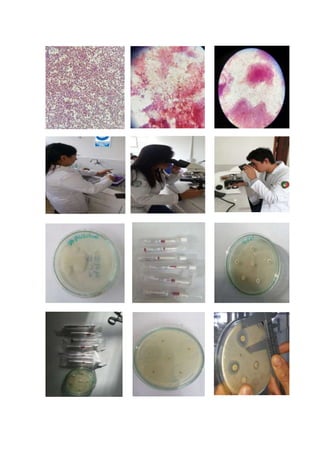

Este documento describe los procedimientos para realizar una necropsia y tomar muestras de laboratorio en aves de corral. El objetivo es evaluar el estado clínico del ave y diagnosticar cualquier enfermedad. Se detallan los pasos para la necropsia, la toma de muestras de sangre, hisopos traqueales y muestras de órganos. También se explican los procedimientos para realizar tinción de Gram, Diff-Quick y un antibiograma para identificar posibles patógenos.